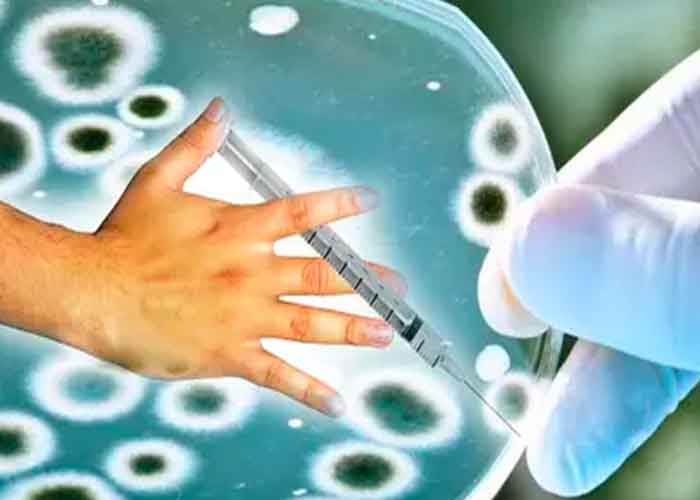

Lima, Perú | AFP | El gobierno de Perú quitó importancia este viernes a la alerta sanitaria causada por los primeros casos de difteria detectados en 20 años y que causaron la muerte de dos personas, indicando que se trataba de un brote menor ya localizado y controlado.
"Hasta el momento la investigación y control nos permite decir que no se ha identificado ningún caso adicional al brote familiar", dijo el viceministro de Salud, Luis Ognio, en una conferencia de prensa.
Sólo se conocen oficialmente cinco casos, dos de ellos mortales, según información pública.
Te puede interesar: Venezuela reporta 80 nuevos casos importados de coronavirus
Las alertas sobre la difteria se encendieron el 27 de octubre, cuando se detectó en Lima el primer caso de difteria en 20 años en medio de la devastadora pandemia del nuevo coronavirus.
Se trataba de una niña de 5 años, sin dosis de vacuna completa, que falleció días después por una complicación cardíaca derivada del tratamiento de la difteria.
Jornada de vacunación
El Ministerio de Salud vacunó entonces a 7.000 personas contra esa enfermedad en la zona donde vivía la menor.
"Esperamos que con la vacunación de las 7.000 personas, se contenga el foco aparecido en La Victoria", el distrito de Lima donde vivía la víctima, añadió el viceministro.
Respecto al segundo caso mortal el miércoles, también en Lima, una mujer de 69 años, las autoridades sanitarias lo matizaron e instaron a la población a la calma descartando contagios y señalando que no producía toxinas.
"No hay ninguna razón para generar una alarma nacional ni es necesario hacer una jornada de vacunación específica para difteria en estos momentos", agregó Suárez.
También puedes ver: Salud de El Salvador investiga cuatro muertes vinculadas a dengue
El viceministro de Salud dijo que la alerta epidemiológica vigente "significa que todos los servicios de salud del país deben estar atentos y hasta el momento no se han identificado nuevos casos".
Perú tiene previsto este fin de semana una doble jornada de vacunación contra cinco enfermedades, para retomar las campañas suspendidas por la pandemia. Entre las vacunas a inocularse figuran las de la difteria y la influenza.
La difteria afecta principalmente la faringe y puede ser mortal en el 10% de los pacientes. Es una enfermedad aguda que, como el coronavirus, se transmite principalmente por secreciones de personas infectadas. Es causada por el bacilo de Klebs-Löffler (Corynebacterium diphtheriae).